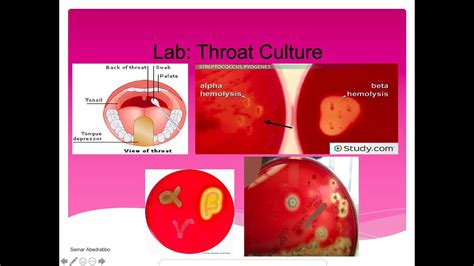

4 Criteria for Strep Throat Diagnosis
4 Criteria for Strep Throat Diagnosis
Reader, have you ever wondered how doctors pinpoint strep throat amidst a sea of sore throat causes? It’s a crucial distinction, as strep throat requires specific treatment. This guide sheds light on the 4 criteria for strep throat diagnosis, providing a comprehensive understanding for accurate identification.
I’ve spent years analyzing the nuances of strep throat diagnosis. Let’s delve into the key indicators that differentiate this bacterial infection from other ailments. These criteria help ensure prompt and effective treatment.
 Physical Examination for Strep Throat
Physical Examination for Strep Throat
- Visual Inspection and Palpation
Visual Inspection of the Throat
The doctor will visually examine your throat for characteristic signs of strep throat. These include redness, swelling of the tonsils, and the presence of white patches or streaks of pus on the tonsils or the back of the throat. This visual inspection is a crucial first step.
The appearance of the throat provides essential clues. Inflammation and the presence of exudate (pus) suggest a bacterial infection. This aligns with the key symptoms of strep throat.
While visual inspection is informative, it’s not definitive. Other conditions can mimic strep throat’s appearance, hence the need for further evaluation using the 4 criteria for strep throat diagnosis.
Palpating the Lymph Nodes
Swollen and tender lymph nodes in the neck are another telltale sign of strep throat. The doctor will gently palpate (feel) the lymph nodes under your jaw and along the sides of your neck to check for enlargement and tenderness. This palpation is a key component of the physical exam.
Lymph nodes are part of the immune system, and they often swell in response to infection. Tender and enlarged lymph nodes strengthen the suspicion of strep throat.
Combining the visual inspection with lymph node palpation provides a more comprehensive picture. However, 4 criteria for strep throat diagnosis necessitate further investigation.
 Rapid Strep Test
Rapid Strep Test
- Quick and Convenient Testing
Administering the Test
The rapid strep test is performed in the doctor’s office and provides quick results. A swab is used to collect a sample from the back of your throat. This sample is then tested for the presence of Streptococcus pyogenes, the bacteria that causes strep throat.
The rapid strep test is highly specific. This means that a positive result is a very strong indicator of strep throat.
However, this test is not perfect. It is crucial to consider all 4 criteria for strep throat diagnosis for a conclusive assessment.
Interpreting the Results
A positive rapid strep test usually confirms the diagnosis. A negative result doesn’t necessarily rule out strep throat. In such cases, a throat culture is often recommended for a definitive diagnosis.
The rapid strep test plays a vital role in quickly identifying strep throat. Fast diagnosis enables prompt treatment.
Understanding the 4 criteria for strep throat diagnosis helps patients and healthcare professionals make informed decisions about treatment.
Throat Culture
Throat Culture
- Definitive Diagnosis
Performing a Throat Culture
A throat culture involves collecting a sample from the back of the throat. This sample is then placed in a special dish to allow any bacteria present to grow. This process takes longer than a rapid strep test, typically 24-48 hours.
A throat culture is considered the gold standard for diagnosing strep throat. It’s highly sensitive and specific, providing accurate results.
While it takes longer, a throat culture is crucial when the rapid strep test is negative, and suspicion of 4 criteria for strep throat diagnosis remains high.
Analyzing the Culture Results
If Streptococcus pyogenes bacteria grow in the culture, the diagnosis of strep throat is confirmed. If no strep bacteria grow, the sore throat is likely due to a viral infection or another cause.
The throat culture helps distinguish strep throat definitively from other conditions. This enables targeted treatment and avoids unnecessary antibiotic use.
Considering the 4 criteria for strep throat diagnosis ensures accurate identification and appropriate treatment strategies.
Symptoms Evaluation for Strep Throat
- Recognizing Key Indicators
Classic Strep Throat Symptoms
Certain symptoms are highly suggestive of strep throat. These include a sudden sore throat, painful swallowing, fever, headache, body aches, and sometimes a rash. These symptoms are crucial indicators.
Experiencing several of these symptoms together increases the likelihood of strep throat. However, symptoms alone aren’t enough for a definitive diagnosis.
It’s important to consider all 4 criteria for strep throat diagnosis to accurately determine the cause of the sore throat. This ensures appropriate treatment.
Differentiating from Other Conditions
While these symptoms point towards strep throat, they can also overlap with other illnesses, like viral infections. Viral infections often present with a runny nose, cough, and congestion, which are less common in strep throat.
Distinguishing between bacterial and viral sore throats is crucial, as they require different treatment approaches. Antibiotics are effective against strep throat but not viral infections.
By evaluating symptoms in conjunction with the other 3 criteria—physical examination, rapid strep test, and throat culture—doctors can accurately diagnose and treat strep throat. This detailed analysis ensures appropriate management of the condition.
Detailed Table Breakdown of Strep Throat Diagnostic Criteria
| Criterion | Description | Significance |
|---|---|---|
| Physical Examination | Visual inspection of the throat for redness, swelling, and pus; palpation of neck lymph nodes for tenderness and enlargement. | Provides initial clues suggesting strep throat. |
| Rapid Strep Test | Quick in-office test detecting strep bacteria in a throat swab. | Offers a rapid, though not always definitive, diagnosis. |
| Throat Culture | Laboratory test growing bacteria from a throat swab to confirm strep throat. | Provides the most accurate and definitive diagnosis. |
| Symptoms Evaluation | Assessment of characteristic symptoms like sore throat, fever, headache, and body aches. | Contributes to the overall clinical picture and guides further testing. |
FAQ about 4 Criteria for Strep Throat Diagnosis
What if the rapid strep test is negative, but I still have symptoms?
A negative rapid strep test doesn’t definitively rule out strep throat. A throat culture is recommended for confirmation, especially if symptoms persist or worsen. The 4 criteria for strep throat diagnosis are considered together.
This approach ensures accurate diagnosis even when the rapid test is negative. It highlights the importance of the throat culture as a definitive diagnostic tool.
Understanding this process helps in managing symptoms and seeking appropriate medical care. This provides clarity on the next steps to take.
Can strep throat resolve on its own without antibiotics?
While strep throat might resolve on its own, antibiotics shorten the duration of symptoms and reduce the risk of complications. Complications can include rheumatic fever or kidney disease. Treatment based on the 4 criteria for strep throat diagnosis is crucial.
Following medical advice and completing the prescribed antibiotic course is essential. This prevents potential complications and ensures complete recovery.
Adhering to treatment guidelines based on the 4 criteria for strep throat diagnosis promotes better health outcomes. This proactive approach minimizes risks.
How contagious is strep throat, and how can I prevent its spread?
Strep throat is highly contagious. It spreads through close contact with respiratory droplets from an infected person. Practicing good hygiene, like frequent handwashing, covering coughs and sneezes, and avoiding sharing personal items, is crucial for prevention.
These preventive measures limit the spread of infection. Implementing them helps protect oneself and others from strep throat.
Understanding the contagion and prevention methods aids in maintaining a healthy environment. This awareness empowers individuals to take protective steps.
Conclusion
So, understanding the 4 criteria for strep throat diagnosis—physical examination, rapid strep test, throat culture, and symptom evaluation—is paramount for accurate identification and prompt treatment. This comprehensive approach ensures effective management of the infection. We’ve explored the key elements of each criterion, providing a thorough guide to this common ailment.
Be sure to check out other informative articles on our site for more insights into health and wellness. Bookmark our blog and stay up-to-date with the latest information on managing various health concerns. We offer a wealth of resources to empower you on your health journey.
.
Sore throat? 4 key criteria help diagnose strep throat quickly & accurately. Learn how doctors differentiate it from a viral infection. Get informed now!





